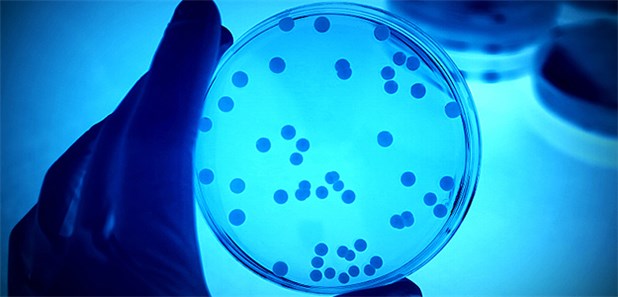
Fast neun Millionen nosokomiale Infektionen jährlich

Eine nosokomiale Infektion (von altgriechisch νόσος nósos, deutsch ‚Krankheit‘ sowie κομεῖν komein, deutsch ‚pflegen‘), Hospitalinfektion oder Krankenhausinfektion (griechisch Nosokomeion bzw. lateinisch Nosocomium für ‚Krankenhaus‘) ist eine Infektion, die im Zuge eines Aufenthalts oder einer Behandlung in einem Krankenhaus oder einer Pflegeeinrichtung auftritt. Laut Definition der nosokomialen Infektion darf der Infektionstag, d. h. der Tag mit dem ersten Symptom, frühestens der Tag 3 des Krankenhausaufenthaltes sein.
Im Rahmen der deutschen nationalen Punkt-Prävalenzerhebung zu nosokomialen Infektionen und Antibiotika-Anwendung 2022 (PPS 2022) wurde bei 3,9 % der Patienten einer repräsentativen Krankenhausstichprobe eine Krankenhausinfektion festgestellt. Die häufigsten Krankenhausinfektionen waren in diesem Rahmen postoperative Wundinfektionen (Anteil von 23,5 %), Infektionen der unteren Atemwege (21,6 %), Harnwegsinfektionen (19,0 %) und primäre Blutstrominfektion (6,7 %).
Mit 17 % war die Prävalenz nosokomialer Infektionen auf Intensivstationen in allen an der PPS 2022 beteiligten Krankenhäusern deutlich höher als auf Nicht-Intensivstationen mit 4,3 %.
Die Rate von Krankenhausinfektionen wird unter anderem von folgenden Faktoren beeinflusst:
- der Altersstruktur der Krankenhauspatienten;
- der Häufigkeit und Schwere von Begleiterkrankungen, insbesondere solchen mit Schwächung der körpereigenen Infektionsabwehr;
- dem Einsatz operativer Techniken bzw. apparativer, invasiver Maßnahmen bei vorher nicht oder schlecht behandelbaren Erkrankungen;
- der Durchführung therapeutischer Maßnahmen, die die Abwehrkraft herabsetzen;
- dem Wissenstand des Fachpersonals in den Krankenhäusern zum Thema Hygiene und Infektionsvermeidung; u. a. gilt die Beschäftigung von Fachärzten für Hygiene in den Krankenhäusern als Mittel zur Senkung der Krankenhausinfektionsrate;
- der Krankenhausorganisation;
- die Größe des Krankenhauses (Anzahl Betten);
- Personalmangel;
- Antibiotika-Einsatz, insbesondere Breitspektrum-Antibiotika
Am Ende des 20. Jahrhunderts hat der hohe Antibiotikaeinsatz in der Behandlung von bakteriellen Infektionskrankheiten zu einer deutlichen Zunahme von multiresistenten Problemerregern geführt: Methicillin-resistenter Staphylococcus aureus (MRSA), Vancomycin-resistente Enterokokken (VRE) und weitere, wobei die häufigsten Erreger nosokomialer Infektionen unter dem Sammelbegriff ESKAPE-Pathogene (Enterococcus faecium, Staphylococcus aureus, Klebsiella pneumoniae, Acinetobacter baumannii, Pseudomonas aeruginosa und Enterobacter) geführt werden. Der vermehrte Einsatz von Breitspektrum-Antibiotika steht mit der Zunahme von multiresistenten Erregern in direkter Wechselbeziehung. Zunehmend verkompliziert sich demzufolge auch die antibiotische Therapie von Hospitalinfektionen, wobei häufig mehr als ein Arzneimittel appliziert werden muss.
Etymologie
„Nosokomeion“ hieß die Räumlichkeit in den Heilstätten im alten Griechenland (z. B. in Epidauros), in denen Patienten mittels eines Heilschlafes behandelt wurden. Der Ausdruck bezeichnet bis heute im weitesten Sinne ein „Krankenhaus“ (im Gegensatz zu „Klinik“, die sich von „Kline“, der Liege ableitet).
Epidemische Lage und klinische Relevanz
Krankenhausinfektionen machen einen Großteil aller im Hospital auftretenden Komplikationen aus und haben daher einen signifikanten Einfluss auf die Qualität der medizinischen und krankenpflegerischen Versorgung der Patienten. Entsprechend müssen sie als ein ernstzunehmendes Problem eines jeden Krankenhauses erkannt werden. Im Krankenhaus erworbene Infektionen belasten nicht nur den Patienten selbst aufgrund der damit verbundenen Schmerzen und Beschwerden, sie verlängern meist auch den Krankenhausaufenthalt – je nach Art der Infektion im Durchschnitt um vier Tage – und führen damit zumindest in solchen Gesundheitssystemen, in denen nach Fallpauschalen abgerechnet wird, zu deutlichen betriebswirtschaftlichen Einbußen. Die wichtigste Maßnahme zur Vermeidung ist die regelmäßige Durchführung einer hygienischen Händedesinfektion mit Händedesinfektionsmitteln.
Bei den meisten aufgeführten Studien handelt es sich um Prävalenz-Untersuchungen. Sie erfassen zu einem bestimmten Zeitpunkt die Häufigkeit von nosokomialen Infektionen. Aus hohen Infektionsraten direkt Konsequenzen zu ziehen, ist bei dieser Form der Erfassung nur selten möglich, weshalb auch die prospektive, kontinuierliche Überwachung (Erfassung von Infektionen und deren Risikofaktoren) favorisiert wird.
Die Interpretation von epidemiologischen Daten über Krankenhausinfektionen ist kompliziert, weil zwischen den exogen (extrinsisch) bedingten, vermeidbaren Infektionen und den endogen (intrinsisch) bedingten kaum oder nur teilweise unterschieden werden kann. Der Vergleich zwischen Krankenhäusern oder auch Fachdisziplinen ist problematisch, da stets berücksichtigt werden muss, nach welchen Kriterien (z. B. Falldefinitionen) die Daten erhoben wurden und ob die Patientenpopulationen bezüglich der Risikofaktoren vergleichbar sind.
Studien zeigten, dass das Risiko, eine Krankenhausinfektion zu erwerben, in Kliniken mit geringeren Bettenzahlen niedriger ist als in größeren. Dieses Faktum ist auch nicht verwunderlich, da in Schwerpunktkliniken mit großen und spezifischen Fachdisziplinen erhöhte diagnostische und aggressive therapeutische Interventionen angewendet werden, weshalb auch mit höheren Inzidenzraten von Krankenhausinfektionen zu rechnen ist. Auf Intensivpflegestationen und auch in operativen Fachdisziplinen ist die Wahrscheinlichkeit, an Krankenhausinfektionen zu erkranken, ebenfalls deutlich erhöht.
Die häufigsten Arten nosokomialer Infektionen auf der Intensivstation sind die beatmungsassoziierte Pneumonie, intraabdominelle Infektionen nach einem Trauma oder nach chirurgischen Eingriffen und Bakteriämien durch intravasale Fremdkörper.
USA
In den USA ist der Anteil an Klinikinfektionen von 1975 bis 1995 um 36 % angestiegen; von 7,2/1000 auf 9,8/1000 Patienten im Jahre 1995. In Kliniken der USA erwerben 5 bis 15 % der Krankenhauspatienten und 25–50 % der Patienten in Intensivpflegestationen eine nosokomiale Infektion. Nach Aussagen des Institute of Medicine in Washington, D.C. sind Krankenhausinfektionen in den USA im Jahr für 44.000–98.000 Todesfälle verantwortlich. In den USA verursachen nosokomiale Infektionen pro Jahr Kosten von 17 bis 29 Milliarden US-Dollar. Im Zeitraum von 1980 bis 1992 hat die Todesursache „Infektion“ in den USA um 58 % zugenommen. Zur Anzahl der Todesfälle, die als Folge einer nosokomialen Infektion auftraten, existieren bislang nur wenige Studien, meist aus den USA. In diesen Studien wurde ermittelt, dass etwa ein Prozent dieser Patienten mittelbar oder unmittelbar daran verstarben. Bei 2,7 % aller ins Krankenhaus aufgenommenen Patienten trugen Infektionen als Mitursache zu einem tödlichen Verlauf bei, waren jedoch nicht die eigentliche Todesursache.
Europa
Das Europäische Zentrum für die Prävention und die Kontrolle von Krankheiten (ECDC) gibt in seinem Bericht zur Prävalenz-Erhebung zu nosokomialen Infektionen und dem Einsatz von Antibiotika in europäischen Akutkrankenhäusern – 2022–2023 rund 4,3 Millionen nosokomiale Infektionen pro Jahr in Europa an, Stand 2024.
Italien
In Italien sterben jedes Jahr zwischen 4500 und 7000 Menschen an Infektionen, die sie sich während eines Klinikaufenthaltes zugezogen haben. Damit dürfte Italien im europäischen Durchschnitt liegen. Das ECDC gibt in seinem Bericht 50.000 zuschreibbare Todesfälle pro Jahr in Europa an.
Deutschland
Während das endemische Niveau nosokomialer Infektionen in Deutschland durch Prävalenzerhebungen und die Surveillance im Rahmen des Krankenhaus-Infektions-Surveillance-Systems ermittelt und beschrieben wird, ist das epidemische Auftreten nosokomialer Infektionen seit Inkrafttreten des Infektionsschutzgesetzes (IfSG) im Jahr 2000 meldepflichtig. In der Urfassung war noch das „gehäufte Auftreten“ ohne ausdrückliche Festlegung meldepflichtig, nach dem Gesetzeswortlaut der ab 25. Juli 2017 geltenden Fassung ist bereits das Auftreten von „zwei oder mehr“ nosokomialen Infektionen, bei denen „ein epidemischer Zusammenhang wahrscheinlich ist oder vermutet“ wird, nichtnamentlich zu melden. (§ 6 Absatz 3 IfSG) Solche Infektionen können beispielsweise in Krankenhäusern, Pflegeeinrichtungen oder Arztpraxen auftreten. Ein „epidemischer Zusammenhang“ besteht, „wenn sich aus den Gesamtumständen schließen lässt, dass das Auftreten von gleichen Krankheitsbildern bei verschiedenen Patienten miteinander in Verbindung steht“. Nosokomiale Infektion wird in § 2 Nummer 8 IfSG definiert als „eine Infektion mit lokalen oder systemischen Infektionszeichen als Reaktion auf das Vorhandensein von Erregern oder ihrer Toxine, die im zeitlichen Zusammenhang mit einer stationären oder einer ambulanten medizinischen Maßnahme steht, soweit die Infektion nicht bereits vorher bestand“.
Nach Schätzungen von 2016 entwickeln in Deutschland pro Jahr ca. 400 000 bis 600 000 Patienten eine nosokomiale Infektion. Es wird deutschlandweit von 1 000 bis 4 000 Todesfällen durch multiresistente Erreger ausgegangen.
Auf Grundlage der Prävalenz-Erhebung zu nosokomialen Infektionen und dem Einsatz von Antibiotika in europäischen Akutkrankenhäusern – 2022–2023 schätzen die Experten des Europäischen Zentrums für die Prävention und die Kontrolle von Krankheiten die jährlichen Anzahl von Patienten, die sich in deutschen Akutkrankenhäusern mindestens eine nosokomiale Infektion zuziehen auf etwa 580 000.
Krankenhausinfektionen verursachen im Mittel vier Tage längere Liegezeiten sowie Zusatzkosten von 4.000 bis 20.000 Euro pro Patient.
Österreich
Die epidemische Lage für Österreich ist vergleichbar mit Deutschland. Ebenso wie in Deutschland oder anderen Ländern der Europäischen Union liegen keine präzisen Zahlen über die Häufigkeit von nosokomialen Infektionen in Einrichtungen des Gesundheitswesens oder gar Todeszahlen von Patienten, die unmittelbar an der direkten Folge von Nosokomialen Infektionen versterben, vor. Laut Österreichischer Gesellschaft für Krankenhaushygiene (ÖGKH) liegt dies – mit Ausnahme von bakteriellen Durchfallserkrankungen durch Clostridium difficile – daran, dass zwar bestimmte Infektionserkrankungen meldepflichtig sind, aber deren direkte Zuordnung nicht immer eindeutig feststellbar ist. Andererseits treten jährlich Infektionen auf, deren ursächlicher Zusammenhang mit diagnostischen oder therapeutischen Tätigkeiten im Gesundheitswesen offenkundig ist, die jedoch im Einzelnen keiner Meldepflicht unterliegen. Dies trifft beispielsweise für die Gruppe der sog. „device assoziierten Infektionen“ (Katheter-assoziierte Harnwegsinfekte, Katheter-assoziierte Bakteriämien, Beatmungs-assoziierte Lungenentzündung) zu.
Eine Ausnahme bilden in Österreich postoperative Wundinfektionen, welche ursächlich in Verbindung mit Behandlungen in einer Einrichtung des Gesundheitswesens entstanden sind. Diese werden mittels einer strukturierten und standardisierten Infektionserfassung vom ANISS-Netzwerk (Austrian Nosocomial Infection Surveillance System) jährlich erfasst. Aktuell melden 42 Krankenanstalten mit 66 teilnehmenden chirurgischen Abteilungen in anonymisierter Form ihre Operationsdaten an ANISS, wobei 17 unterschiedliche Indikatoroperationen erfasst werden. Da ANISS sich methodisch an der Europäischen Infektionserfassung HELICS orientiert, sind somit auch Vergleiche zwischen den einzelnen Mitgliedsstaaten möglich.
Demnach treten in Österreich postoperative Wundinfektionen nach Herz-Bypass-Operationen mit einer Inzidenzdichte von 1,2 Infektionen pro 1000 PT (postoperative Patiententage) auf, was der exakt selben Inzidenzdichte wie in Deutschland entspricht. Der Europäische Schnitt liegt bei 1,6, die höchste Inzidenzdichte wurde für 2007 aus Spanien gemeldet (3,8 Infektionen/1000 PT), die niedrigste aus Norwegen mit 0,4 Infektionen/1000 PT.
Ein vergleichbares Bild findet sich bei postoperativen Wundinfektionen nach einer Hüftendoprothesen-Operation. Hier treten Infektionen wieder mit derselben Inzidenzdichte wie Deutschland (0,6 Infektionen/1000 PT) auf, was genau dem Europäischen Schnitt entspricht. Die höchste Infektionsdichte nach Hüftendoprothesen-Operationen fand sich in Ungarn (2,4 Infektionen/1000 PT), die niedrigste in Frankreich (0,3 Infektionen/1000 PT).
Insgesamt werden derzeit in Österreich nach Operationen zwischen 2 % und 25 % aller Infektionen auf freiwilliger Basis an das Österreichische Surveillance Netzwerk ANISS gemeldet. Die ÖGKH fordert hierzu wiederholt eine verpflichtende Teilnahme an ANISS und obligate Erfassung und Meldung von relevanten Daten zur Erfassung von postoperativen und „device assoziierten“ Infektionen in Österreich.
Schweiz
In der Schweiz liegt die durchschnittliche Ansteckungsrate bei 5,9 %. Geschätzte 70.000 Personen erkranken in Schweizer Spitälern jährlich an healthcare-assoziierten Infektionen (HAI), zirka 2.000 sterben daran.
Weitere Länder
Die Zahlen stimmen mit den Erfahrungen anderer Länder überein. So wurden aus dem Vereinigten Königreich zuletzt 320.000 Infektionen gemeldet, in den Vereinigten Staaten sind es sogar 1,7 Millionen pro Jahr.
Pathogenese und Komplikationen nosokomialer Infektionen
Im Rahmen invasiver medizinischer Maßnahmen (Apparatemedizin) werden immer häufiger Fremdkörper in den Patienten eingeführt, die gerade bei längerer Liegezeit als Quelle nosokomialer Infektionen fungieren. Invasive medizinische Hilfsmittel spielen eine weitaus größere Rolle für die Entstehung von nosokomialen Infektionen als die Grundkrankheiten der Patienten. Die Mehrzahl der Risikoanalysen für die Entstehung nosokomialer Infektionen hat klare Ergebnisse erbracht, dass die Erreger, seien sie empfindlich oder multiresistent, bei chirurgischen Eingriffen oder bei der Anwendung invasiver Hilfsmittel in den Körper gelangen. Bei diesen Hilfsmitteln handelt es sich beispielsweise um Venenkatheter als Auslöser für nosokomiale Septikämien, Blasenkatheter als Auslöser nosokomialer Harnwegsinfektionen, Endotracheale Intubation und apparative Beatmung als Auslöser für Beatmungspneumonien oder um Liquorableitungen als Auslöser für Meningitiden.
Gefäßzugänge, insbesondere zentrale Venenkatheter, spielen hierbei zahlenmäßig die Hauptrolle. Sie sind für knapp zwei Drittel der in US-Krankenhäusern auftretenden nosokomialen Infektionen verantwortlich. Schlüsselereignis in der Pathogenese dieser Infektionen ist zunächst eine Anheftung von Mikroorganismen an das Plastikmaterial der Katheter. Daran schließt sich häufig die Erzeugung einer schleimigen Matrix durch die Erreger an. Der so entstandene Biofilm ist gekennzeichnet durch erhöhte Resistenz, verminderte Kultivierbarkeit, kooperative Strategien und hohe Diversität der Mikroorganismen.
Aus jeder nosokomialen Infektion kann sich eine schwere systemische Infektion, die Sepsis als schwerste Verlaufsform oder schwere systemische Komplikation, entwickeln. Im Rahmen der Immunabwehr wird eine Entzündungsreaktion (SIRS = systemische inflammatorische Antwort oder systemic inflammatory response syndrome) in Gang gesetzt mit dem Ziel, die Eindringlinge (Bakterien, Pilze, Viren und Parasiten) zu vernichten. Hierbei kommt es zu einer überschießenden Freisetzung inflammatorischer Zytokine (Mediatorenexplosion), deren Wirkungen den Makroorganismus schwerwiegend schädigen können. Trotz intensivmedizinischer Behandlung sterben mehr als die Hälfte der Patienten an einer nosokomialen Sepsis, besonders dann, wenn sich ein septischer Schock mit nachfolgendem Multiorganversagen entwickelt hat. Die nosokomiale Sepsis wird oft als die Crux der modernen Intensivmedizin bezeichnet.
Infektionsursachen und Prävention
Nach dem Infektionsschutzgesetz müssen in Deutschland alle Einrichtungen des Gesundheitswesens, insbesondere
- Krankenhäuser,
- Einrichtungen für ambulantes Operieren,
- Vorsorge- oder Rehabilitationseinrichtungen, in denen eine den Krankenhäusern vergleichbare medizinische Versorgung erfolgt,
- Dialyseeinrichtungen,
- Tageskliniken,
- Entbindungseinrichtungen,
- Behandlungs- oder Versorgungseinrichtungen, die mit einer der in den Nummern 1 bis 6 genannten Einrichtungen vergleichbar sind,
- Arztpraxen, Zahnarztpraxen und
- Praxen sonstiger humanmedizinischer Heilberufe
sicherstellen, dass die nach dem Stand der medizinischen Wissenschaft erforderlichen Maßnahmen getroffen werden, um nosokomiale Infektionen zu verhüten und die Weiterverbreitung von Krankheitserregern, insbesondere solcher mit Resistenzen, zu vermeiden. Nach dem Gesetzestext wird die Einhaltung des Standes der medizinischen Wissenschaft auf diesem Gebiet vermutet, wenn jeweils die veröffentlichten Empfehlungen der Kommission für Krankenhaushygiene und Infektionsprävention beim Robert Koch-Institut und der Kommission Antiinfektiva, Resistenz und Therapie beim Robert Koch-Institut beachtet worden sind. Eine Überprüfung dieser Pflichten kann durch die Gesundheitsämter erfolgen (§ 23 IfSG, Abs. 6).
Finale Kette und Kausalität
In der Regel ist zu vermuten, dass eine finale Kette zwischen Kontaktpersonen, insbesondere Pflegepersonal und Besuchern, Kontakten mit diesen Personen und den Infektionen der Patienten besteht. Hingegen gelingt es in vielen Fällen nicht, die Kausalität nachzuweisen. Das zeigt: Auch durch technische Maßnahmen lassen sich naturgemäße Schwächen medizinischer Versorgung, die immer einen direkten Kontakt zum Patienten erfordert, nicht beheben. Insoweit bleibt die medizinische Leistung eine Dienstleistung mit der Pflicht des Bemühens, aber ohne Gewähr für den Erfolg.
Eine Verbesserung des Outcome für Patienten ist daher eher durch systematische Prävention in der klinischen Routine zu erreichen, beispielsweise durch Beachtung der elementaren Händedesinfektion, durch Reduktion der Frequenz der Zu- und Ausgänge von Personen und durch qualifizierte periodische Reinigung der Räume einschließlich der Belüftungsanlagen mit anschließender Sterilisation vor erneuter Benutzung wie im OP-Bereich üblich. Der entsprechende Aufwand für jede Prävention ist allemal geringer als die Kosten für die Behebung eines Erregerbefalls im einzelnen Fall und der auch finanziell wirksame Reputationsverlust für die jeweilige Klinik.
Beatmungsassoziierte Pneumonien
Beatmungsassoziierte Pneumonien stellen sowohl in Deutschland als auch international die häufigste nosokomiale Infektionsart auf der Intensivstation dar.
In Deutschland zeigen aktuelle Daten des Krankenhaus-Infektions-Surveillance-Systems (KISS), dass die Pneumonierate auf Intensivstationen derzeit bei etwa neun bis elf Episoden pro 1000 Beatmungstage liegt. Hochgerechnet für Deutschland erleiden pro Jahr 30.000 Patienten auf Intensivpflegestationen eine Pneumonie. Hierdurch entstehen nicht nur erhebliche Mehrkosten aufgrund des verlängerten Intensivaufenthaltes, auch die persönliche Prognose des betroffenen Patienten wird deutlich eingeschränkt.
Es war lange Zeit umstritten, wie die Erreger einer Beatmungspneumonie in die Lunge gelangen. Heute weiß man, dass es sich entweder um Erreger aus dem Milieu der Intensivstation handelt, die durch Hygienefehler in die Mundhöhle des Patienten transportiert werden (exogener Infektionsweg), oder aber um Erreger aus dem eigenen Magen des Patienten, die durch „Hochschwappen“ von Mageninhalt die Mundhöhle erreichen (endogener Infektionsweg).
Der endogene Infektionsweg ist in seiner Bedeutung in den letzten Jahren deutlich zurückgetreten, seitdem sich für Beatmungspatienten die Oberkörperhochlagerung mit einem Winkel von etwa 30–45° zur Unterlage durchgesetzt hat. Aus der Mundhöhle gelangen die Erreger durch Mikroaspirationen in die Luftröhre und die tieferen Luftwege. Der weitere Ablauf der Entstehung beatmungsassoziierter Pneumonien führt über das Eindringen der Erreger in den Bronchialbaum zunächst zu einer tracheobronchialen Besiedlung. Erst unter bestimmten Bedingungen, wie beispielsweise einer Schwächung der Abwehrlage des Patienten, kommt es dann schließlich zur Durchbrechung der alveolokapillären Membran (Alveolarschranke) und zur Ausbildung einer Gewebsentzündung.
Präventionsmaßnahmen zur Verhinderung einer mikrobiellen Besiedelung des Magendarmtraktes und der Atemwege
- Penible Beachtung der Händehygiene vor und nach jeder Manipulation am Beatmungssystem sowie vor und nach dem Absaugen
- Beatmungsschläuche und geschlossene Absaugsysteme nicht routinemäßig, sondern nur bei Funktionsstörungen oder sichtbarer Verschmutzung wechseln
- In-line-Beatmungsfilter (Heat Moisture Exchanger, HME) nicht bei Patienten mit starker Sekretproduktion oder Hämoptysen verwenden
- HME-Filter alle 24 Stunden oder bei sichtbarer Verschmutzung wechseln
- Bei Entleerung der Wasserfallen exogene Kontamination des Inneren der Beatmungsschläuche vermeiden
Präventionsmaßnahmen zur Verhinderung der Aspiration kontaminierter Sekrete
- Druck des Tubus-Cuffs regelmäßig prüfen und aufrechterhalten
- Halbaufrechte Lagerung des Patienten mit einem Winkel von etwa 30°, auch bei Transporten
- Wasserfallen leeren vor Patientenumlagerung
- Um eine Magenüberdehnung zu vermeiden, vor jeder Nahrungs- oder Flüssigkeitszufuhr stets Magenfüllungszustand durch Aspiration prüfen
- Nasogastrische Magensonde so bald wie möglich entfernen
Präventionsmaßnahmen beim Absaugen
- Bei geschlossenem Absaugsystem: Saubere Einmalhandschuhe verwenden. Bei offener Absaugung: Sterile Handschuhe
- Absaugkatheter in sauberer und trockener Umgebung lagern
- Absaugkatheter nicht auf das Beatmungsgerät legen
- Katheter zur oralen Absaugung sollten nicht in Papierfolienverpackung, sondern in einer sauberen wiederverschließbaren Verpackung gelagert werden
- Nur bei wirklichem Bedarf absaugen. Durch zu häufige Absaugung können Erreger in die Atemwege gelangen
Andere wesentliche Punkte
- Nasalen Intubationsweg vermeiden
- Beatmungstubus sicher befestigen, damit er nicht versehentlich vom Patienten gezogen werden oder herausrutschen kann
- Doppelte oder dreifache Antibiotikatherapie vermeiden
- Die medikamentöse Stressulcusprophylaxe wird kontrovers diskutiert, ein abschließendes Ergebnis steht noch aus.
- Mundrachenraum täglich mit Chlorhexidinlösung spülen (nur bei kardiochirurgischen Patienten)
- Impfungen durchführen (Influenza, Pneumokokken, Hämophilus Typ b)
Katheterassoziierte Harnwegsinfektionen
Harnwegsinfektionen stehen in vielen Statistiken über die Häufigkeit nosokomialer Infektionen an erster Stelle. In den USA entwickeln etwa drei Prozent aller Krankenhauspatienten bzw. 15 Prozent aller mit einem Blasenkatheter versorgten Patienten eine Harnwegsinfektion. Bei zehn bis 15 Prozent der Patienten mit Harnwegsinfektion kommt es zu sekundären Komplikationen wie einer Sepsis bis hin zum septischen Schock. Ob durch eine Harnwegsinfektion auch die Letalität der Krankenhauspatienten steigt, ist strittig. Für die USA wurde hochgerechnet, dass etwa 50.000 Todesfälle in Krankenhäusern auf Harnwegsinfektionen zurückzuführen sind.
Folgende Empfehlungen zur Überwachung, Vorbeugung, Diagnostik und Behandlung der Harnwegsinfektionen sind nach Methoden der evidenzbasierten Medizin gut abgesichert:
- Eine Erfassung (Surveillance) von asymptomatischen Bakteriurien ist für Patienten in Langzeitpflegeeinrichtungen nicht erforderlich.
- Für die Erfassung symptomatischer Harnwegsinfektionen sollten standardisierte diagnostische Kriterien (CDC-Definition) verwendet werden.
- Die Häufigkeit nosokomialer Harnwegsinfektionen soll als Infektionsrate/1000 Patiententage bzw. /1000 Harnwegskathetertage angegeben werden.
- Kondomkatheter sollten bei begründeter Indikation bei Männern dem transurethralen Blasenkatheter vorgezogen werden.
- Wenn irgend möglich, sollten intermittierende Einmalkatheterisierungen gegenüber einer Langzeiturinableitung bevorzugt werden.
- Keine Aussage zum routinemäßigen Wechsel von Langzeit-Harnwegskathetern und zum optimalen Zeitpunkt eines Wechsels.
- Die Therapie von Harnwegsinfektionen sollte stets mit Antibiotika erfolgen. Lokale Desinfizienzien sind obsolet.
- Die Therapiedauer sollte maximal zehn bis 14 Tage betragen, kürzere Zyklen können für Frauen mit geringer klinischer Symptomatik empfohlen werden.
- Bei rezidivierender symptomatischer Harnwegsinfektion kann eine durchgehende Therapie von 6 Wochen erwogen werden.
- Es ist nicht erforderlich, nach Beendigung der Antibiotikatherapie eine zweite Kultur zur Dokumentation des Therapieerfolgs abzunehmen.
Postoperative Wundinfektionen
Wundinfektionen nach Operationen gehören zu den häufigsten nosokomialen Infektionen, in einer 2011 in Deutschland durchgeführten Erhebung machten sie einen Anteil von 24,3 % der nosokomialen Infektionen aus und lagen damit noch vor Harnwegsinfektionen (23,2 %) und unteren Atemwegsinfektionen (21,7 %).
Die eigene Bakterienflora des Patienten ist dabei die häufigste Infektionsquelle. Die Infektion findet meist während des Eingriffs statt, dies gilt sowohl für endogene (aus der Bakterienflora des Patienten selbst stammende) als auch für exogene (z. B. vom Operationspersonal stammende) Infektionen. Die häufigsten Erreger sind Bakterien der Art Staphylococcus aureus (Anteil in o. g. Studie von 2011 19,8 %), außerdem spielen koagulasenegative Staphylokokken, Enterobakterien, Enterokokken und gramnegative (obligate) Anaerobier eine Rolle. Auch Pilze (insbesondere der Art Candida albicans) kommen als Auslöser vor.
Es gibt zahlreiche Risikofaktoren für postoperative Wundinfektionen, die zunächst in endogene (patienteneigene) und exogene (außerhalb des Patienten liegende) unterteilt werden. Zu den gesicherten endogenen Risikofaktoren gehören z. B. höheres Lebensalter, Abwehrschwäche, schwere Begleitkrankheiten, Infektionen an anderen Körperstellen sowie eine Besiedlung der Nase mit Staphylococcus aureus. Zu den gesicherten exogenen Risikofaktoren zählt man unter anderem die Art der Haarentfernung vor der Operation, die Art des operativen Eingriffs (Kontaminationsklassen sauber, sauber-kontaminiert, kontaminiert oder schmutzig), Verzicht auf Antibiotika-Prophylaxe bei Hoch-Risiko-Eingriffen und die Dauer der Operation. Die Häufigkeit postoperativer Wundinfektionen unterscheidet sich in verschiedenen operativen Fächern, sie ist z. B. in der Augenheilkunde und Zahnmedizin niedrig und in der Bauch- und Herzchirurgie höher.
Zur Prävention kommen unter anderem baulich-technische Maßnahmen zur Anwendung. Hierunter versteht man z. B. die bauliche Trennung der Operationsabteilungen vom übrigen Krankenhausbereich (u. a. durch Schleusen) sowie Raumlufttechnische Anlagen. Die Wirksamkeit dieser Maßnahme ist aber begrenzt, da bereits heute wie oben erwähnt in Industrieländern wie Deutschland die Quelle nosokomialer Wundinfektionen meist die Bakterienflora des Patienten und nicht die Umgebung ist.
Weiterhin stellen Expertenempfehlungen zur Prävention postoperativer Wundinfektionen Maßnahmen wie z. B. Verzicht auf Haarentfernung vor der Operation (wenn möglich), Durchführung einer Antibiotikaprophylaxe (nur bei entsprechendem Risikoeingriff, dann in der Regel einmalig zu Beginn der Operation) und korrekte Hautdesinfektion (Antiseptik) vor der Operation in den Vordergrund.
Katheter-assoziierte Infektionen durch zentralvenöse Katheter
In den USA werden jährlich mehr als 5 Millionen zentralvenöse Katheter gelegt. Obwohl ihre Anwendung für die parenterale Ernährung, die Messung des zentralen Venendrucks und die Zufuhr von Medikamenten in vielen Fällen unabdingbar ist, sind sie andererseits eine der häufigsten Quellen von Komplikationen und nosokomialen Infektionen. Je nach Liegedauer und Kathetertyp kommt es bei etwa 5–26 % der Katheter zur Lokalinfektion oder Sepsis. Jedes Jahr treten alleine in den USA 250.000 bis 500.000 Bakteriämien im Zusammenhang mit Gefäßkathetern auf. Zwei Drittel aller Ausbrüche von nosokomialen Bakteriämien oder Candidämien haben einen Gefäßkatheter als Ursache, aber auch die Mehrzahl der endemisch auftretenden nosokomialen Bakteriämien sind Katheter-assoziiert. Studien haben gezeigt, dass das Vorhandensein eines Venenkatheters mit einer erhöhten Inzidenz nosokomialer Bakteriämien bedingt ist.
Das Vorhandensein eines Katheters ist auch der wichtigste einzelne Risikofaktor für das Auftreten einer nosokomialen Candidämie oder einer Bakteriämie durch Staphylococcus aureus. Prospektive Studien haben auch gezeigt, dass Katheter-assoziierte Sepsis zu einer erheblichen Verlängerung des Krankenhausaufenthaltes führt, auch wenn die Anzahl und Schwere der Grundkrankheiten als weiterer Einflussfaktor berücksichtigt und herausgerechnet wird.
Die durchschnittliche Verlängerung der Liegedauer im Vergleich zu gleichaltrigen Kontrollpatienten ohne Sepsis beträgt zehn bis 20 Tage. Hieraus resultieren erhöhte Krankenhauskosten in Höhe von 4000 bis maximal 56.000 US-$ pro Sepsisepisode. Von besonders schwerwiegender Bedeutung ist die Tatsache, dass Patienten mit Katheter-assoziierter Sepsis bzw. Bakteriämie eine erhöhte Letalität aufweisen. Im Vergleich zu gleichaltrigen Kontrollpatienten mit vergleichbar schwerer Grundkrankheit beträgt die zusätzliche Letalität 12–35 %.
Ein weiterer, die Letalität bestimmender Einflussfaktor ist der auslösende Erreger: Der Nachweis von Staphylococcus aureus geht mit einer Katheter-assoziierten Sepsisletalität von 22 bis 43 % einher, der Nachweis von Candida spp. in einigen Studien sogar mit einer Letalität bis zu 67 %. Katheter-assoziierte Septikämien mit weniger pathogenen Erregern wie koagulasenegativen Staphylokokken und Enterokokken waren dagegen nur in einigen Studien, aber nicht immer, mit einer erhöhten Letalität assoziiert.
Vor jeder Katheterinsertion steht zunächst die Entscheidung, welches Kathetermaterial bzw. welcher Kathetertyp angewandt werden soll. Neben den konventionellen Kathetern aus Polyurethan werden bereits seit einigen Jahren sowohl auf dem US-Markt als auch in Deutschland antimikrobiell beschichtete Katheter angeboten. In Deutschland sind bisher lediglich Katheter, die außenseitig mit Chlorhexidin und Silbersulfadiazin beschichtet sind, sowie reine Silberkatheter im Handel. In den USA existieren auch Katheter, die mit Antibiotika (Rifampicin und Minocyclin) imprägniert sind. Hintergrund für die Entwicklung dieser Katheter war die Tatsache, dass die Mehrzahl der Katheter-assoziierten Infektionen durch eine außenseitige Kolonisation der Katheterspitze hervorgerufen werden. Seit 2006 sind diese auch auf dem deutschen Markt erhältlich.
Randomisierte klinische Studien haben gezeigt, dass die außenseitig mit Chlorhexidin und Silbersulfadiazin beschichteten Katheter in der Lage sind, die Infektionsrate von 7,6 Septikämien pro 1000 Kathetertage (4,6 % der Katheter) auf 1,6 Septikämien pro 1000 Kathetertage (1 % der Katheter) zu senken.
Unter laufender Infusionstherapie sollten folgende Maßnahmen der Infektionsprävention beachtet werden:
- Hygienische Händedesinfektion vor jeder Manipulation am Katheter
- Katheterkonus und Dreiwegehähne vor Diskonnektion desinfizieren
- Infusionssystemwechsel alle 72 Stunden
- Verbandwechsel unter Einhaltung aseptischer Kautelen, entweder mit Gaze oder als Transparentverband
- Kein routinemäßiger Austausch des Katheters nach einer bestimmten Liegedauer
- Keine Anwendung von antibiotikahaltigen Salben an der Insertionsstelle.
Die Diagnose einer katheter-assoziierten Infektion erfolgt durch klinische Zeichen (Fieber, Rötung bzw. Entzündung an der Einstichstelle, Besserung nach Entfernung des Katheters), die jedoch unzuverlässig sind und mikrobiologische Untersuchungen (Keimzahlbestimmung an Katheterspitze, Blutkulturen).
Siehe auch
- Antibiotikum-Resistenz
- Desinfektion
- Hospitalismus
- MRSA
- Robert Koch-Institut
- iatrogen
Literatur
- Marianne Abele-Horn: Antimikrobielle Therapie. Entscheidungshilfen zur Behandlung und Prophylaxe von Infektionskrankheiten. Unter Mitarbeit von Werner Heinz, Hartwig Klinker, Johann Schurz und August Stich, 2., überarbeitete und erweiterte Auflage. Peter Wiehl, Marburg 2009, ISBN 978-3-927219-14-4, passim.
- Richard Rathgeber: Nosokomiale Infektionen: Organisationspflichten und rechtliche Verantwortlichkeit. In: Schriften zum Medizinstrafrecht. Nr. 18. Nomos, Baden-Baden 2021, ISBN 978-3-7489-2627-6, doi:10.5771/9783748926276 (nomos-elibrary.de [abgerufen am 11. April 2022] Dissertation, Erlangen-Nürnberg, Universität, 2021).
Weblinks
- Literatur von und über Nosokomiale Infektion im Katalog der Deutschen Nationalbibliothek
- BT-Drs. 18/3600: Bericht der Bundesregierung vom 18. Dezember 2014 über nosokomiale Infektionen und Erreger mit speziellen Resistenzen und Multiresistenzen
- KISS (Krankenhaus-Infektions-Surveillance-System) des Nationalen Referenzzentrums für Surveillance von nosokomialen Infektionen in Deutschland
Einzelnachweise